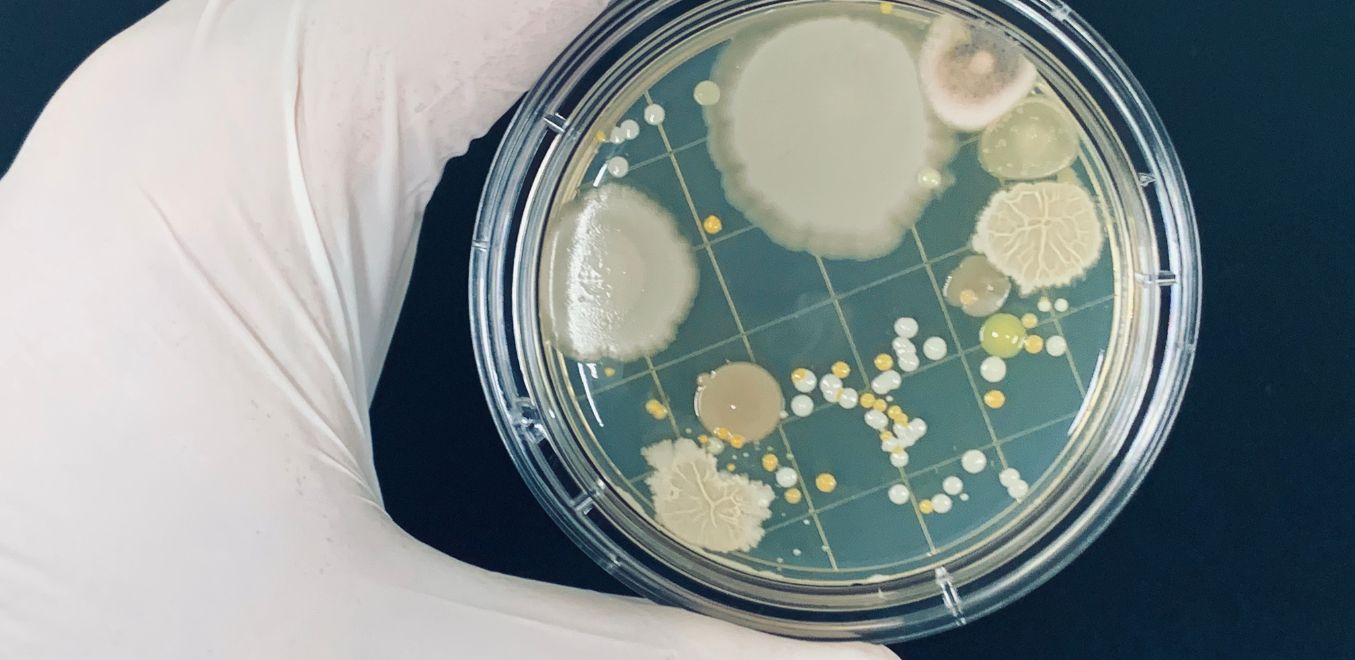

Globally trusted partner
We specialize in Exporting
Oleochemicals, Food and Cosmetic Ingredients, Pharmaceuticals,
Veterinary Raw Materials, Solvents, and Allied Chemicals.

Fatty Esters
- Isopropyl palmitate (IPP)
- Isopropyl myristate (IPM)
- Medium chain triglyceride (MCT Oil)
- Glycerol mono stearate, GMS 40 & GMS 95

Fatty Alcohols
- Lauryl-Myristyl alcohol C1214
- Cetyl alcohol C1698
- Stearyl alcohol C1898
- Cetyl-Stearyl alcohol C1618 (30:70)
- Cetyl-Stearyl alcohol C1618 (50:50)

Soap Noodles
(Snow White & Natural White)
- Toilet Soap Noodles (70:30/ 80:20/ 90:10)
- Multipurpose Soap Noodles (90:10) – (TFM - 70%, 72%, 74%)
- Laundry Soap Noodles (TFM - 60%, 64%, 70%)

Surfactants
- Sodium Lauryl Ether Sulphate (SLES)
- Coco Amido Propyl betaine (CAPB)
- Cocodiethanolamide (CDE)

Glycerol
- Rened glycerine 99.5% min USP/BP/EP grade Crude glycerine 80%

Vitamins
- Tocotrionol (Available in Powder, Oil and Capsule)

Fatty Acids
- Caprylic acid C8 99%
- Lauric acid C12 99%
- Myristic acid C14 99%
- Palmitic acid C16 98% / C16 80%
- Stearic acid C18 90% / C18 92% / C18 95%
- Stearic acid triple pressed C1837 / C1845 / C1850 / C1865
- Stearic acid rubber grade
- Oleic acid 50% & 75%

Surfactants & Solvents
- Nonyl Phenol Ethoxylates (NPE) - 4/6/9/9.5/10 Moles
- Linear Alkylbenzene Sulfonic Acid
- (LABSA) - 90% & 96%
- Sodium Lauryl Ether Sulfate (SLES) -70%
- Sodium Lauryl Sulphate (SLS)
- Butyl Glycol
- Diethanolamine (DEA)
- Triethanolamine (TEA)
- Monoethanolamine (MEA)
- Diethylene Glycol (DEG)
- Monoethylene Glycol (MEG)
- Polyethylene Glycol (PEG) - 200/300/400/600

Food & Pharma
- Guar Gum
- Polysorbate-20/60/80
- Xanthan Gum
- Glycine Food Grade
- Glacial Acetic Acid
- Phosphoric Acid 85% -Food Grade
- Soy Lecithin
- Caffeine Anhydrous Natural/Synthetic
- Sodium Saccharin
- Propylene Glycol USP

Antioxidant & Preservative
- Butylated Hydroxy Toluene (BHT) - Food Grade
- Butylated Hydroxy Anisole (BHA)
- Castor Oil
- Sodium Benzoate
- Salicylic Acid
- Sodium Gluconate
- Sorbic Acid
- Sodium Metabisulfite - Food Grade
- Sodium Bicarborate - Food Grade

Cosmetics & Personal Care
- Cetostearyl Alcohol 30:70
- Cetostearyl Alcohol Ethoxylated 20 Moles
- Cetyl Alcohol
- Polyquaternium 7
- Cocamido Propyl Betaine (CAPB) -KA 30

Moisturizer
- Liquid Paraffin (Mineral Oil USP)
- White Soft Paran
- Emulsifying Wax Anionic/Non-Ionic

Industrial Applications
- Chlorinated Parafin 50%
- Phosphrous Acid 98.5%

Laxative, Additive
- Sorbitol 70% Non-Crystallizing USP
- Sorbitol 70% Crystalline

Disinfectants, Sanitizers & Personal Care
- Chlorohexidine di Gluconate 20%
- Benzalkonium Chloride (BKC) - 50% & 80%

Personal Care & Neutralizing Agent
- Glyoxylic Acid
- Minoxidil

Dietary Supplement
- Calcium Saccharate
- Dibasic Calcium Phosphate Anhydrous

Flavour
- Ethyl Vanillin
- Vanillin

Expectorant
- Menthol Crystal

Fumigant Insecticide
- Para-Dichlorobenzene (PDCB)

Iron Deficiency
- Ferrous Fumarate
Anti-microbial Agent
- Triclosan

Acidulant & Flavour Enhancer
- Mallic Acid

Pharma Application
- Potassium Iodide

Intermediates
- Oxalic Acid

Antiseptic
- Povidone-Iodine

Anti-inflammatory & Pain Reliever
- Sodium Salicylate

Food & Additive
- Mono Potassium Phosphate (MKP) - Food Grade Di Potassium Phosphate (DKP) - Food Grade Taurine
- Maize Starch

Dental Application
- Calcium Glycerophosphate

Pharma Application
- Potassium Iodide

Sweetener
- Dextrose Monohydrate/Anhydrous Mannitol
We pride ourselves on being a trusted partner .
There are so many reasons to choose Us
Unmatched Product Quality
We are committed to delivering only the highest quality chemicals that meet global standards.
Global Reach with Local Expertise
We are able to serve clients across the globe while maintaining a deep understanding of local market needs.
Customer-Focused Approach
Your success is our priority. From custom solutions and technical support to timely deliveries

Let’s collaborate
Get in Touch with Us
Fill out the form below, and our team will get back to you promptly.

